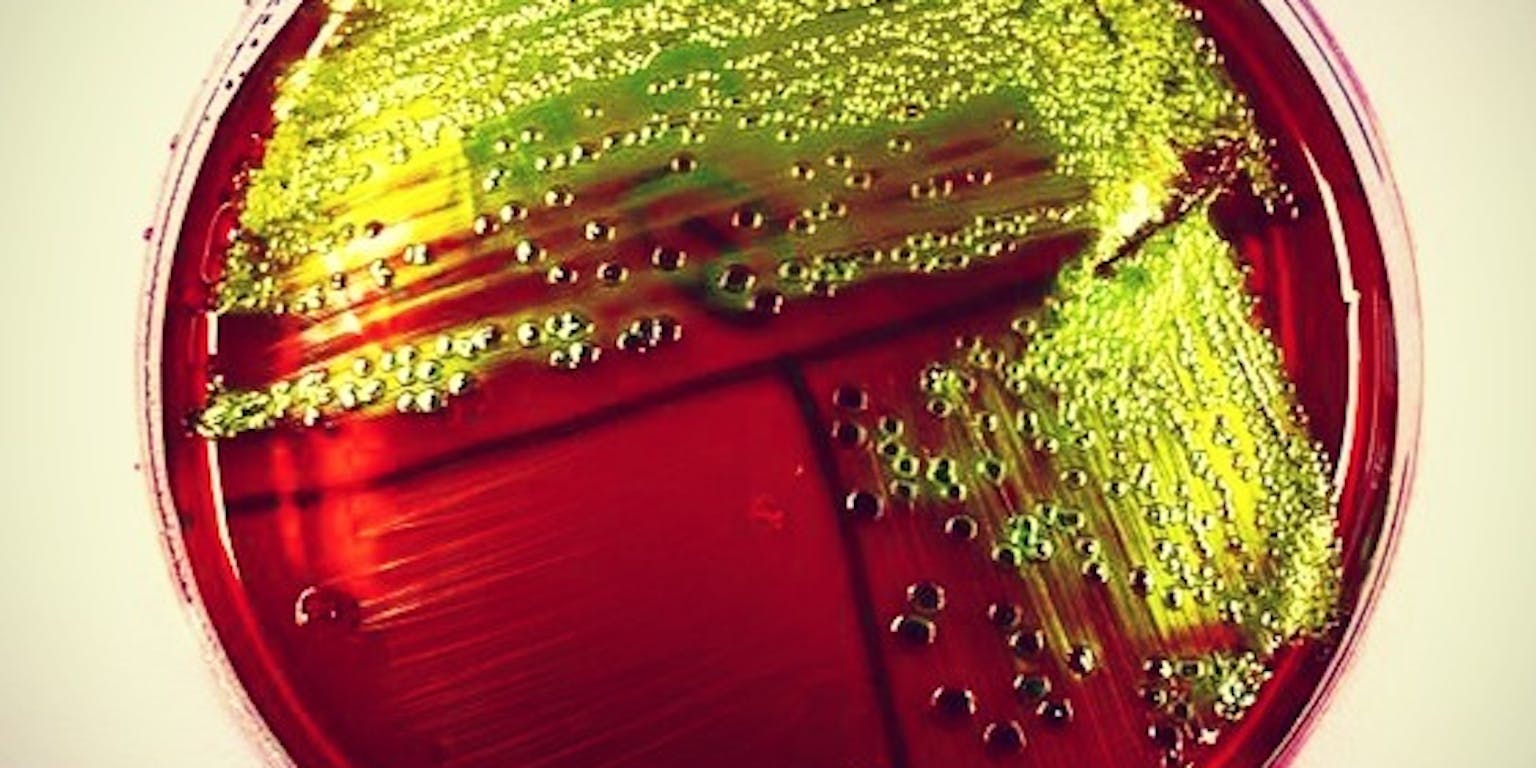

Hoe groot een bacterie wordt, hangt af van de snelheid waarmee de cel een complete cyclus doorloopt ten opzichte van de snelheid waarmee de cel groeit. Dit is de kern van een nieuwe ‘algemene groeiwet’ voor cellen die Amerikaanse onderzoekers publiceerden in het tijdschrift Current Biology. Ze geven hiermee een uitbreiding van een zestig jaar oude wet die niet algemeen genoeg was.

Bacteriën kampen niet met angst voor overgewicht. Eten wat je kunt, is het devies. Dus als er ‘rijkere’ voeding beschikbaar is, worden ze groter. Zijn er alleen ‘magere’ voedingsbronnen, dan blijven ze klein. Zou je denken. Maar zo simpel is het niet. De omvang van bacteriën is namelijk niet direct gekoppeld aan de samenstelling van het voedingsaanbod, maar aan de groeisnelheid. Dat is het tempo waarin de bacteriën zich delen. Zolang ze even snel delen, worden bacteriën ook op verschillende voedingsbronnen even groot.
Deze koppeling tussen celgrootte en groeisnelheid werd ongeveer zestig jaar geleden al beschreven en staat bekend als een van de ‘groeiwetten’. Vele experimentele studies laten zien dat de groeiwet klopt in omstandigheden waarin de hoeveelheid voedsel beperkt is. Er zijn echter ook andere factoren die de grootte van een cel beïnvloeden, maar tot dusver is er nog geen model in geslaagd om die mechanismen goed te verklaren.
Snel delen of snel groeien?
Dat is jammer, want inzicht in hoe groot een bacterie wordt, is nuttig voor verschillende toepassingen waarbij voedselgebrek niet aan de orde is. Bijvoorbeeld als je bacteriën gebruikt als producent van geneesmiddelen, vitaminen of andere waardevolle stoffen. Dan moeten de bacteriën niet al hun energie besteden aan de voorplanting; ze moeten vooral flink groeien. Meer groei betekent meer biosynthese (aanmaak van eiwitten en andere biomoleculen) en dus hoe meer product.
We weten ook dat het blokkeren van de biosynthese van bepaalde eiwitten zorgt voor een toename of afname van het celvolume, afhankelijk van wat je blokkeert en hoe je dat doet. Er is dus een koppeling tussen de biosynthese en de celgrootte. Maar de oude groeiwet geeft hiervoor geen houvast. Hoogste tijd voor een herziening van de wet zodat die meer algemeen toepasbaar is, vonden natuurkundige Suckjoon Jun en zijn team van de Universiteit van Californië in San Diego. In het tijdschrift Current Biology publiceerden ze hun nieuwe, uitgebreide versie van de oude groeiwet. Die blijft overigens nog steeds geldig onder specifieke omstandigheden, maar wordt onderdeel van een meer algemene wet.
Hoe groot de cel wordt, hangt volgens Suckjoon Jun en zijn collega’s af van de verhouding tussen de tijd die het kost om een volledige celcyclus te doorlopen en de tijd die een cel nodig heeft om zijn hoeveelheid biomassa, en daarmee zijn gehele omvang, te verdubbelen. Met biomassa bedoelen we hier alles wat de cel produceert, behalve het DNA.
Dit lijkt misschien ingewikkeld, maar onder normale omstandigheden verlopen de celcyclus en de verdubbeling van het volume precies even snel. Dus als het DNA is gekopieerd en een cel klaar is om te delen, is het totale volume twee keer zo groot geworden. Dat laat deze formule ook zien: Ƭcyc en Ƭ zijn dan gelijk, waardoor S = S0 x 2. Een keurige verdubbeling van het uitgangsformaat dus.
Maar als om wat voor reden ook Ƭcyc en Ƭ uit de pas lopen, dan heeft dat direct gevolgen voor het uiteindelijke celvolume. Als Ƭcyc kleiner is dan Ƭ neemt de cel in omvang af. De celcyclus loopt dan sneller dan de groei in biomassa, waardoor de cel al gaat delen voordat het volume is verdubbeld. De cel wordt dus kleiner. Andersom geldt het natuurlijk ook. Als een cel veel langer doet over het kopiëren van het DNA en het in gang zetten van de celdeling, heeft de cel ook de tijd om ondertussen flink te groeien. Het volume zal meer dan verdubbelen vóór de deling; de cel wordt groter.
Biomassa luistert niet
Dat de celcyclus en de aanmaak van biomassa niet altijd hand in hand gaan is geen nieuws. Maar het werk van Jun en collega’s levert voor het eerst een algemeen geldend model voor deze waarnemingen, zegt Greg Bokinsky, assistant professor Bionanowetenschappen aan de TU Delft. Bokinsky doet zelf onderzoek naar de productie van biomassa door bacteriën en reageert op verzoek van NEMO Kennislink op de publicatie van Jun. “We weten dat de productie van biomassa niet ‘luistert’ naar het DNA-replicatie proces, maar we hadden geen model waarin die observatie past. Nu is duidelijk waarom we dit zien en dat het een algemeen verschijnsel is.”
De kracht van de aanpak van Jun zit volgens Bokinsky in het gebruik van geavanceerde moleculair-biologische technieken, zoals de genetische kniptechniek CRISPR, om experimenteel aan te tonen dat biosynthese en DNA-replicatie niet direct gekoppeld zijn. “Ze zijn erin geslaagd om de onderliggende biochemische processen te ontkoppelen, waardoor je de relatie tussen de verschillende processen en de celgrootte kunt bestuderen. Het is ze bijvoorbeeld gelukt om gericht de DNA-replicatie te vertragen, dat vind ik heel cool. Ze laten zien dat er nu veel nieuwe ‘knoppen’ zijn om aan te draaien als je iets wilt bijstellen. Voorheen hadden we alleen grove methoden zoals de voeding variëren of antibiotica gebruiken, maar dan weet je nooit precies wat je allemaal beïnvloedt.”
Gaswet
De wet oogt heel simpel en elegant. In hoeverre heb je echt iets aan zo’n algemene wet als je onderzoek doet naar zoiets ingewikkelds en gevarieerds als levende cellen? “Algemene wetmatigheden gebaseerd op observaties geven weliswaar geen verklaring op moleculair niveau, maar ze zijn wel degelijk nuttig”, aldus Bokinsky.
Hij vergelijkt het met bekende wetten uit de natuurkunde zoals de wet van Hooke, die stelt dat de kracht in een uitgerekte veer kwadratisch toeneemt met de uitrekking. Of de algemene gaswet, die de relatie geeft tussen druk, volume en temperatuur van een gas. “Zulke wetmatigheden helpen je om verder te komen, ze geven een raamwerk om je eigen hypothesen en oplossingen aan te toetsen. Als het hier niet aan voldoet, hoef je er niet mee verder. Zo zie ik ook dit werk van Jun. Een cel is zo complex dat je eindeloos veel verklaringen kunt bedenken voor je experimentele data. Dankzij zo’n wet kun je snel selecteren welke verklaringen er niet toe doen en welke de moeite waard zijn.” Totdat er weer een nieuwe wetmatigheid opduikt natuurlijk.